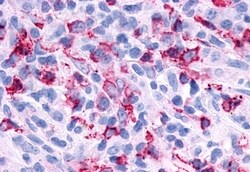
Invitrogen P2Y6 Polyclonal Antibody 50 &mu;g; Unconjugated:Antibodies,

missing translation for 'onlineSavingsMsg'
Learn More
Learn More
Invitrogen™ P2Y6 Polyclonal Antibody


Rabbit Polyclonal Antibody
Brand: Invitrogen™ PA534093
This item is not returnable.
View return policy
Description
Percent identity with other species by BLAST analysis: Human, Gorilla, Orangutan, Gibbon, Monkey, Marmoset, Rat, Hamster, Bovine, Rabbit, Pig (100%).
P2Y6 belongs to the family of G protein coupled receptors. This family has several receptor subtypes with different pharmacological selectivity, which overlaps in some cases, for various adenosine and uridine nucleotides. This receptor is responsive to UDP, partially responsive to UTP and ADP, and not responsive to ATP. P2Y6 expression has been documented in various blood cells, bone marrow, brain, colon, heart, kidney, ovary, placenta, spleen and thymus. ESTs have been isolated from cervix, embryo, eye, kidney, liver/spleen, placenta, and vessel libraries.
Specifications
| P2Y6 | |
| Polyclonal | |
| Unconjugated | |
| P2ry6 | |
| 2010204J23Rik; G-coupled nucleotide receptor; MGC15335; P2 purinoceptor; P2ry6; P2Y ATP receptor 6; P2Y purinoceptor 6; p2y3 and chick; p2y3 receptor; P2Y6; P2Y6 receptor; PP2891; Purinoceptor p2y6; pyrimidinergic receptor P2Y, G-protein coupled, 6; pyrimidinergic receptor P2Y6 | |
| Rabbit | |
| Antigen affinity chromatography | |
| RUO | |
| 100358580, 100512849, 100752781, 117264, 5031, 539703 | |
| Store at 4°C short term. For long term storage, store at -20°C, avoiding freeze/thaw cycles. | |
| Liquid |
| Immunohistochemistry (Paraffin) | |
| 1 mg/mL | |
| PBS with 0.1% sodium azide | |
| Q15077, Q63371 | |
| P2ry6 | |
| Synthetic 17 amino acid peptide from 2nd cytoplasmic domain of human P2RY6 / P2Y6. | |
| 50 μg | |
| Primary | |
| Human, Rat, Rabbit, Monkey, Bovine, Hamster, Pig | |
| Antibody | |
| IgG |
Product Content Correction
Your input is important to us. Please complete this form to provide feedback related to the content on this product.
Product Title
Spot an opportunity for improvement?Share a Content Correction